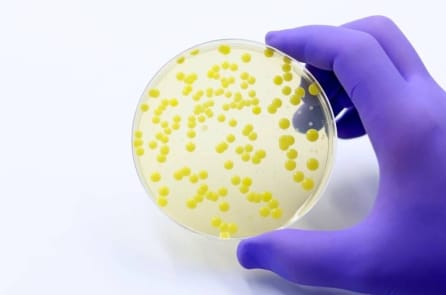
Các quan chức y tế cảnh báo sự gia tăng của loại vi khuẩn kháng thuốc nguy hiểm

EPA cảnh báo: Silicon D4 là mối nguy hiểm với con người và động vật hoang dã
Các cơ quan quản lý tại Hoa Kỳ cho biết rằng D4 – một hóa chất được sử dụng để sản xuất các sản phẩm silicon từ tấm pin mặt trời đến mỹ phẩm –…

FDA phê duyệt liệu pháp mới cho ung thư vú tiến triển
Ngày 25/ 9, FDA đã phê duyệt một liệu pháp mới cho ung thư vú tiến triển, dựa trên dữ liệu từ thử nghiệm lâm sàng giai đoạn 3. Nghiên cứu: Loại dầu hạt phổ…

Đồ uống có đường thúc đẩy di căn ung thư đại trực tràng
Việc tiêu thụ đồ uống có đường chứa chất tạo ngọt fructose và glucose có thể làm tăng nguy cơ ung thư đại trực tràng di căn trong cơ thể, theo một nghiên cứu mới…

Quan chức Florida công bố khoản đầu tư mới vào điều trị ung thư, bao gồm Ivermectin
Vào hôm 24/9, các quan chức tiểu bang Florida thông báo sẽ đầu tư 60 triệu USD vào nghiên cứu phòng ngừa và điều trị ung thư, với trọng tâm là dinh dưỡng phòng ngừa…

Khi nào phụ nữ mang thai có thể dùng acetaminophen (paracetamol) giữa những cảnh báo về tự kỷ?
Người đứng đầu Cơ quan Trung tâm Dịch vụ Y tế và Medicaid thuộc Bộ Y tế và Dịch vụ Nhân sinh Hoa Kỳ, Tiến sĩ Mehmet Oz, đã làm rõ hướng dẫn liên bang…
Các quan chức y tế cảnh báo sự gia tăng của loại vi khuẩn kháng thuốc nguy hiểm
Trong những năm gần đây, tại Việt Nam và nhiều quốc gia trên thế giới đã có "sự gia tăng đáng kể” của một chủng vi khuẩn kháng thuốc nguy hiểm. Ibuprofen và Paracetamol; 2…

Leucovorin có thể là một phương pháp điều trị đầy hứa hẹn cho tự kỷ
Vào buổi họp báo hôm thứ Hai, Tổng thống Donald Trump đã công bố một phương pháp điều trị tiềm năng cho bệnh tự kỷ. Theo Giáo sư Quadros tại Đại học SUNY Downstate – người…

Cha mẹ có thể làm gì để chống lại cuộc khủng hoảng sức khỏe ở trẻ nhỏ?
Việc trẻ em ngày càng mắc các bệnh mãn tính không phải là điều khó hiểu, và chắc chắn điều này không phải mới xảy ra gần đây. Đó là kết quả của một lối…

Vượt qua căn bệnh hen suyễn, tìm thấy câu trả lời cho tâm – thân khỏe mạnh
Sinh ra tại Đài Loan trong một gia đình có tiền sử dị ứng nặng, Tiến sĩ ngành dược Lâm Uy Vũ đã phải chống chọi với bệnh hen suyễn từ khi còn nhỏ. Tuổi…

Táo bón: Cách khắc phục từ gốc rễ và những sai lầm thường gặp
Trong nhiều năm, bà Lâm (hóa danh), ngoài 70 tuổi, phải đối mặt với chứng táo bón mạn tính, có khi bốn hoặc năm ngày mới đi tiêu một lần. Bà cũng nhận thấy một…

Bí quyết ăn uống giúp chống nếp nhăn và đốm nâu da
Con người không thể chấm dứt lão hóa cũng như không thể khiến thời gian ngừng trôi, nhưng chắc chắn thực phẩm hàng ngày sẽ phần nào quyết định quá trình này nhanh hay chậm.…

Cứ 40 giây lại có một ca đột quỵ – Hãy cảnh giác với các triệu chứng sau
Ở Việt Nam, mỗi năm có khoảng 200.000 người bị đột quỵ, tức trung bình mỗi giờ có hơn 20 trường hợp mới. Đột quỵ hiện là nguyên nhân gây tử vong hàng đầu và…

Lướt điện thoại khi đi vệ sinh làm tăng nguy cơ mắc bệnh trĩ lên gần 50%
Bác sĩ chuyên khoa tiêu hóa giải thích lý do tại sao chúng ta nên giới hạn thời gian đi vệ sinh trong vòng năm phút. Ngày nay, điện thoại thông minh đã trở thành…

Sự tĩnh lặng: Phương thuốc làm chậm nhịp tim và nuôi dưỡng não bộ
Một cuộc sống hạnh phúc và khỏe mạnh khởi nguồn từ một tâm trí tĩnh lặng. Sự tĩnh lặng không chỉ nuôi dưỡng trái tim và não bộ, mà còn mở ra con đường dẫn…

Cảnh giác với những tác nhân gây đau nửa đầu hằng ngày
Chứng đau nửa đầu ảnh hưởng đến hàng triệu người trên toàn thế giới, gây ra cơn đau dữ dội có thể cản trở công việc, học tập và sinh hoạt hằng ngày. Với bác…

Cố vấn CDC khuyến nghị không nên dùng vắc-xin 4 trong 1 cho trẻ nhỏ
Vào hôm 18/9, Ủy ban Cố vấn về Thực hành Tiêm chủng (ACIP) cho biết CDC không nên khuyến nghị loại vắc-xin phối hợp chống sởi, quai bị, rubella và thủy đậu cho trẻ nhỏ. …

Hút thuốc lá thụ động: Tác hại kéo dài qua nhiều thế hệ
Một nghiên cứu mới cho thấy trẻ em có cha từng hít khói thuốc lá thụ động khi nhỏ có nguy cơ suy giảm chức năng phổi khi trưởng thành cao hơn đáng kể. Có…

Ibuprofen và Paracetamol – 2 loại thuốc phổ biến có liên quan đến kháng kháng sinh
Ibuprofen và acetaminophen (paracetamol) từ lâu là những loại thuốc được sử dụng rộng rãi tại Việt Nam và nhiều nước trên thế giới. Tuy nhiên, nghiên cứu mới công bố ngày 25/8/2025 cho thấy…

Tiêm thuốc tránh thai liên quan đến nguy cơ u não ở phụ nữ
Theo một phân tích trên hơn 10 triệu phụ nữ, depot medroxyprogesterone acetate (DMPA), loại thuốc tránh thai dạng tiêm được hàng triệu phụ nữ sử dụng, có liên quan với nguy cơ mắc u…

Âm nhạc cổ điển có thể hỗ trợ kiểm soát huyết áp
Có lẽ tất cả chúng ta đều yêu thích âm nhạc. Âm nhạc giúp xoa dịu những căng thẳng tâm lý, bất giác khiến chúng ta nhún nhảy theo từng giai điệu. Đặc biệt, âm…




















